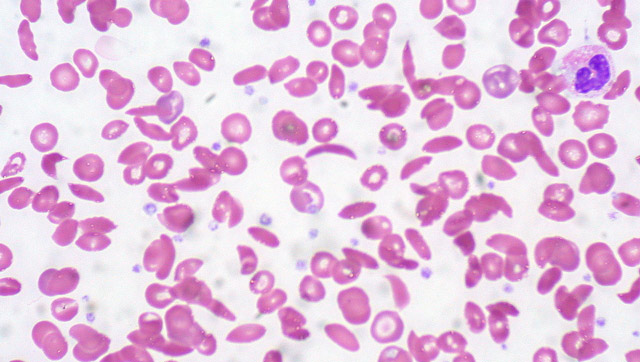

Гемолитическая – от слова «гемолиз»
При гемолитической анемии срок жизни эритроцитов составляет всего 30-50 дней, а в тяжелых случаях — не более двух недель. Для сравнения, нормальная продолжительность жизни красных кровяных клеток составляет 80-120 дней.
Преждевременная массовая гибель клеток — это патологический процесс, известный как гемолиз, который происходит:
- Внутриклеточно (внесосудистый, экстраваскулярный гемолиз) — в селезенке, печени и красном костном мозге (аналогично физиологическому);
- Внеклеточно (интраваскулярный гемолиз) — непосредственно в кровеносных сосудах.
Сокращенный срок жизни эритроцитов, вызванный их массовой досрочной гибелью, приводит к симптомам и негативным последствиям для организма. Внутриклеточный и внеклеточный гемолиз имеют свои специфические признаки, которые можно выявить как визуально, так и с помощью лабораторных исследований.
Гемолитическая анемия представляет собой группу заболеваний, характеризующихся разрушением эритроцитов, что приводит к снижению уровня гемоглобина и кислородного голодания тканей. Врачи выделяют несколько видов этой патологии, включая аутоиммунную, наследственную и микробную анемию. Течение заболевания может варьироваться от легкой формы до тяжелых состояний, требующих немедленного вмешательства. Основные проявления включают усталость, бледность, желтуху и тахикардию.
Диагностика гемолитической анемии основывается на анализах крови, которые показывают уровень гемоглобина, количество ретикулоцитов и наличие билирубина. Врачи также проводят дополнительные исследования для определения причины гемолиза. Принципы лечения зависят от этиологии заболевания и могут включать кортикостероиды, иммуносупрессоры или переливание крови. Важно, чтобы лечение проводилось под наблюдением специалиста, чтобы избежать осложнений и улучшить качество жизни пациента.

Внутриклеточный гемолиз при анемии
Незапланированный гемолиз, вызванный мононуклеарными фагоцитами (макрофагами), чаще всего происходит в селезенке. Больной может заметить его симптомы, обратив внимание на изменения цвета кожи, мочи и кала, что подтверждается клиническими анализами:
- Кожа и слизистые оболочки могут приобрести желтоватый оттенок, а в анализе крови фиксируется повышение уровня билирубина за счет свободной фракции.
- Превращение избыточного свободного билирубина в прямую форму требует участия гепатоцитов (клеток печени), которые нейтрализуют токсичный билирубин. Это приводит к окрашиванию желчи из-за увеличения концентрации желчных пигментов, что может способствовать образованию камней в желчном пузыре и протоках.
- Желчь, насыщенная желчными пигментами, попадая в кишечник, вызывает увеличение стеркобилина и уробилиногена, что объясняет интенсивное окрашивание кала.
- Экстраваскулярный гемолиз также проявляется в моче, где повышается уровень уробилина, придающего ей темный цвет.
- В общем анализе крови (ОАК) наблюдается снижение количества красных кровяных клеток, однако костный мозг компенсирует эти потери, увеличивая количество молодых форм – ретикулоцитов.
| Характеристика | Виды гемолитической анемии | Проявления и течение |
|---|---|---|
| Понятие | Группа анемий, характеризующихся преждевременным разрушением эритроцитов (гемолизом) | Разнообразны, зависят от скорости и степени гемолиза, возраста пациента и сопутствующих заболеваний |
| Классификация по механизму гемолиза | • Внутрисосудистый гемолиз: разрушение эритроцитов в кровотоке (например, при аутоиммунной гемолитической анемии, микроангиопатической гемолитической анемии) • Внутриклеточный гемолиз: разрушение эритроцитов в селезенке, печени и костном мозге (например, при наследственной сфероцитозе, серповидноклеточной анемии) |
• Внутрисосудистый: гемоглобинурия (красная моча), желтуха, снижение артериального давления, острая почечная недостаточность • Внутриклеточный: желтуха, спленомегалия (увеличение селезенки), анемия, слабость, утомляемость |
| Классификация по этиологии | • Наследственные: серповидноклеточная анемия, талассемии, наследственный сфероцитоз, дефицит глюкозо-6-фосфатдегидрогеназы • Приобретенные: аутоиммунная гемолитическая анемия, лекарственная гемолитическая анемия, инфекционная гемолитическая анемия, микроангиопатическая гемолитическая анемия |
• Наследственные: проявления с рождения или раннего детства, часто с семейным анамнезом • Приобретенные: развитие в течение жизни, часто связано с предшествующими заболеваниями или воздействием внешних факторов |
| Диагностика | • Общий анализ крови (снижение гемоглобина, эритроцитов, гематокрита, повышение ретикулоцитов) • Биохимический анализ крови (повышение билирубина, ЛДГ) • Анализ мочи (гемоглобинурия) • Исследование костного мозга • Тест Кумбса (для выявления аутоиммунной гемолитической анемии) • Генетическое тестирование (для выявления наследственных форм) |
Диагноз устанавливается на основании клинической картины, лабораторных данных и результатов специальных исследований |
| Принципы лечения | • Устранение причины гемолиза (например, лечение инфекции, отмена лекарственного препарата) • Трансфузия эритроцитарной массы (при тяжелой анемии) • Спленэктомия (удаление селезенки при некоторых формах) • Иммуносупрессивная терапия (при аутоиммунной гемолитической анемии) • Лекарственная терапия (кортикостероиды, иммуноглобулины) |
Лечение направлено на устранение причины гемолиза, коррекцию анемии и симптоматическую терапию |
Внутрисосудистый гемолиз
Несанкционированный гемолиз в кровеносных сосудах проявляется определенными симптомами и лабораторными признаками разрушения эритроцитов:
- Увеличивается уровень свободно циркулирующего в крови гемоглобина. Оболочки клеток разрушаются, и гемоглобин высвобождается, «окрашивая» кровь.
- Свободный гемоглобин, покидая кровеносное русло и выходя из организма с мочой, может придавать ей различные оттенки: красный, бурый или черный.
- Часть железосодержащего пигмента, образующегося при распаде гемоглобина, остается в организме, откладываясь в паренхиматозных органах и костном мозге (гемосидероз).
Ранее гемолитическую анемию классифицировали по принципу внутрисосудистого или тканевого разрушения красных кровяных клеток. В настоящее время используется другой подход, который делит заболевание на две группы.
Гемолитическая анемия — это состояние, при котором происходит разрушение эритроцитов, что приводит к снижению уровня гемоглобина и кислородной недостаточности. Люди отмечают, что данное заболевание может быть как наследственным, так и приобретённым. Существует несколько видов гемолитической анемии, включая аутоиммунную, микросфероцитарную и наследственную сфероцитарную анемию. Симптомы могут варьироваться от усталости и бледности до желтухи и увеличения селезёнки.
Диагностика включает анализы крови, которые помогают определить уровень гемоглобина и количество эритроцитов, а также тесты на наличие антител. Лечение зависит от причины анемии и может включать кортикостероиды, иммуносупрессоры или даже переливание крови. Важно, чтобы пациенты получали своевременную медицинскую помощь, так как игнорирование симптомов может привести к серьёзным осложнениям.

Полученные по наследству или приобретенные случайно
Современная медицина не разделяет гемолитическую анемию по месту разрушения эритроцитов. Основное внимание уделяется причинам и механизмам развития заболевания. На основе этих критериев анемия делится на два основных типа:
-
Наследственные гемолитические анемии классифицируются в зависимости от локализации генетического дефекта в красных кровяных клетках. Это приводит к их неполноценности, функциональной нестабильности и сокращению срока жизни. К наследственным ГА относятся: мембранные нарушения (микросфероцитоз, овалоцитоз), ферментные дефекты (дефицит Г-6-ФДГ) и гемоглобинопатии (серповидно-клеточная анемия, талассемия).
-
Приобретенные формы ГА классифицируются по факторам, вызывающим разрушение эритроцитов и приводящим к анемии (антитела, гемолитические токсины, механические повреждения).
Наиболее распространенной среди приобретенных ГА является [название анемии]. Она будет подробно рассмотрена позже, после обсуждения наследственных анемий.
Важно отметить, что большая часть гемолитических анемий относится к приобретенным формам, среди которых существует множество подтипов, каждый из которых имеет свои причины возникновения:
- Заболевание может развиваться под воздействием антиэритроцитарных антител, вырабатываемых против собственных антигенов эритроцитов (аутоиммунные – аутоиммунная гемолитическая анемия) или изоантител, поступивших извне (изоиммунная – гемолитическая болезнь новорожденных).
- ГА может возникнуть из-за соматических мутаций, изменяющих мембранную структуру красных кровяных клеток (пароксизмальная холодовая ночная гемоглобинурия).
- Механическое повреждение мембраны эритроцитов может происходить из-за искусственных сердечных клапанов или травмирования клеток в капиллярах стоп при физической активности (маршевая гемоглобинурия).
- Различные химические вещества, чуждые организму (органические кислоты, гемолитические яды, соли тяжелых металлов и др.), могут негативно влиять на мембранные структуры.
- Дефицит витамина Е также может стать причиной развития гемолитической анемии.
- Паразит малярийного плазмодия, проникающий в кровь человека через укус самки комара рода Anopheles (малярийный комар), представляет опасность в контексте возникновения гемолитической анемии как симптома «болотной лихорадки».
Гемолитические анемии, запрограммированные до рождения

Талассемия у детей
Обусловленное наследственным дефектом транспортной РНК или гена-регулятора, изменение скорости синтеза одного из типов (α, β, γ) глобиновых цепей приводит к гемоглобинопатии, известной как талассемия. Наиболее распространена патология, связанная с нарушением синтеза β-цепей, что объясняет широкое распространение β-талассемии. Эта форма проявляется снижением уровня нормального гемоглобина (HbA) и увеличением аномальных вариантов (HbF и HbA2).
Эритроциты с аномальным гемоглобином обладают высокой хрупкостью и неустойчивостью, что делает их подверженными разрушению и гемолизу из-за повышенной проницаемости клеточной мембраны. При попытке пройти через узкие капилляры они часто не справляются, что приводит к симптомам талассемии, которая может протекать в двух формах:
- Гомозиготная форма, известная как тяжелая талассемия, чаще встречается у детей.
- Гетерозиготная форма или малая талассемия – этот вариант чаще выявляется у взрослых, зачастую случайно при анализе крови.
Талассемия — генетическое заболевание, характеризующееся нарушением синтеза нормального гемоглобина. Не стоит углубляться в детали малой талассемии. Благодаря своей гетерозиготной природе, наследуемой по рецессивному типу, она может не проявляться или быть случайно обнаруженной у взрослого человека при анализе ретикулоцитов и осмотической стойкости эритроцитов (что не является частью стандартного общего анализа крови). Гомозиготная форма протекает тяжело, проявляясь у детей в первый год жизни, с неблагоприятным прогнозом и множеством осложнений.
Симптомы болезни Кули:
- Бледность кожи, желтушность, интенсивность которой может варьироваться;
- Общая слабость, вялость, быстрая утомляемость;
- Спленомегалия (увеличение селезенки), что может приводить к значительному увеличению живота ребенка, возможно, также увеличение печени;
- В общем анализе крови низкий уровень гемоглобина при нормальном количестве эритроцитов (гипохромная анемия);
- Задержка психического и физического развития не является обязательным признаком болезни Кули, но такие дети могут позже начинать держать голову, ползать и ходить, а также плохо есть.
При наличии подобных симптомов врачи могут заподозрить гепатит неясной этиологии, однако не забывают и о гемолитической анемии данного типа. Устранить сомнения в отношении гемолитической анемии помогают тщательно собранный анамнез (наличие аналогичных симптомов в семье) и лабораторные исследования (в крови – повышение уровня свободного билирубина, малые фракции HbF и HbA2, ретикулоцитоз; в общем анализе мочи – уробилин).
Лечение гемолитической анемии, вызванной гемоглобиновой аномалией:
- Гемотрансфузии (эритроцитарная масса) при резком снижении уровня гемоглобина;
- Курсы десфералотерапии (для предотвращения гемосидероза);
- Прием фолиевой кислоты;
- Удаление селезенки при значительном увеличении ее размера;
- Пересадка костного мозга.
Внимание! Ферротерапия при талассемии противопоказана!
Маленькие сферические кровяные тельца
Микросфероцитарная мембранопатия, также известная как наследственный микросфероцитоз или болезнь Минковского-Шоффара, — это аутосомно-доминантное заболевание, иногда возникающее из-за спонтанных мутаций. Основная особенность этой патологии — врожденная аномалия мембран и сферическая форма эритроцитов. В норме красные кровяные клетки имеют двояковогнутую форму, что позволяет им легко проходить через узкие участки сосудов. Сфероциты, напротив, не могут пройти в узкие пространства, теряя часть своей мембраны и вызывая гемолиз. Кроме того, мембрана пропускает внутрь клетки избыточное количество ионов натрия, что увеличивает энергозатраты и сокращает срок жизни клеток.
Течение заболевания может быть более тяжелым у новорожденных и менее выраженным у детей старшего возраста. Чем раньше выявляется болезнь, тем тяжелее ее проявления.
Гемолитический синдром — один из основных симптомов заболевания. Он может возникать спонтанно или под воздействием неблагоприятных факторов, таких как физические нагрузки, травмы или холод. Заболевание имеет волнообразный характер: периоды гемолитических кризов чередуются с временным улучшением. Часто болезнь сопровождается другими врожденными аномалиями, такими как «заячья губа», сердечные пороки, башенный череп и патологии внутренних органов.
Среди других симптомов врожденной микросфероцитарной мембранопатии можно выделить:
- Желтуху, интенсивность которой варьируется в зависимости от состояния пациента и течения болезни (при гемолитическом кризе желтуха выражена особенно сильно);
- Слабость (временную или постоянную);
- Лихорадку (в период обострения);
- Мышечные боли и дискомфорт в правом подреберье (в области печени) и селезенки;
- Учащенное сердцебиение, снижение артериального давления и, у некоторых пациентов, шумы в сердце;
- Увеличение селезенки (с течением времени);
- Моча темного цвета, напоминающего пиво, и потемнение кала.
Часто болезнь проявляется желтухой, что может привести к ошибочному диагнозу гепатита. Пациенты попадают в инфекционное отделение, где при лабораторных исследованиях первоначальный диагноз опровергается.
В общем анализе крови наблюдается снижение уровня гемоглобина и количества эритроцитов, которые преимущественно представлены маленькими сферическими клетками.
Следует обратить внимание на следующие показатели:
- Аутогемолиз (значительно повышен);
- Ретикулоциты (увеличены);
- Осмотическая резистентность эритроцитов (заметно снижена);
- Биохимический анализ крови показывает гипербилирубинемию за счет несвязанной фракции;
- Уровни стеркобилина (в кале) и уробилина (в моче) также превышают норму.
Лечение гемолитической анемии данного типа не отличается разнообразием терапевтических подходов. В случаях выраженной анемии возможно проведение гемотрансфузий. Применение препаратов железа, витаминов группы В и гормонов при болезни Минковского-Шоффара нецелесообразно из-за их низкой эффективности. Единственным радикальным методом лечения является удаление селезенки, что значительно улучшает состояние пациента, хотя неполноценные эритроциты продолжают циркулировать в крови.
Другие аномалии, полученные по наследству
Наследственные гемоглобинопатии (ГА) не ограничиваются приведенными примерами. Однако из-за их редкости, схожести симптомов, подходов к лечению и идентичности диагностических критериев для всех форм, мы оставим дифференциальную диагностику специалистам. Позвольте сделать несколько заключительных замечаний о наследственных ГА.
Серповидноклеточная анемия во многом напоминает талассемию, но отличается значительной гибелью эритроцитов во время кризов, что приводит к гемолизу. У детей серповидноклеточная болезнь может быть спровоцирована инфекциями и вызывать серьезные осложнения, такие как параличи, легочный инфаркт, кардиомегалию и цирроз печени. У взрослых заболевание несколько «успокаивается», но риск осложнений остается высоким.
Наследственный овалоцитоз (эллиптотоз) проявляет симптомы, схожие с микросфероцитозом, но отличается от него структурой красных кровяных клеток.
Наследственный дефект эритроцитов — дефицит активности Г-6-ФДГ (глюкозо-6-фосфатдегидрогеназа) связан с нарушением выработки энергии.
Это заболевание может проявляться в любом возрасте, включая новорожденных. Гемолитическая болезнь новорожденных с ядерной желтухой, возникающая из-за недостатка Г-6-ФДГ, имеет тяжелое течение и выраженную неврологическую симптоматику. Диагностические критерии аналогичны тем, что применяются при микросфероцитозе.
Заболевание может протекать по-разному: от бессимптомного до тяжелых гемолитических кризов, которые обычно вызываются приемом определенных медикаментов, беременностью, инфекциями или аллергенами. Неправильно распознанный гемолитический криз с резким снижением уровня гемоглобина может привести к серьезным осложнениям, таким как ДВС-синдром или острая почечная недостаточность, и имеет неблагоприятный прогноз.
Аутоиммунная гемолитическая анемия (АИГА) – приобретенное «самоедство»
Аутоиммунная гемолитическая анемия
Аутоиммунная гемолитическая анемия (АИГА) — это заболевание, при котором организм вырабатывает антитела против антигенов собственных красных кровяных клеток. Иммунная система ошибочно воспринимает свои антигены как чуждые и начинает с ними бороться.
Существует два основных типа АИГА:
- Симптоматическая аутоиммунная гемолитическая анемия, возникающая на фоне других заболеваний (гемобластозы, хронические гепатиты, новообразования, системная красная волчанка, ревматоидный артрит, лимфогранулематоз и др.);
- Идиопатическая форма АИГА, которая может быть вызвана различными факторами (инфекции, прием медикаментов, травмы, беременность, роды). Эти факторы не являются прямыми причинами заболевания, но могут приводить к связыванию гаптена с поверхностью эритроцита, что вызывает выработку антител. Обычно этот гаптен остается незамеченным.
Чистая форма АИГА — это идиопатический вариант, часто развивающийся после родов, абортов, пищевых отравлений или неупорядоченного приема некоторых лекарств.
Патогенез АИГА проходит два этапа:
- Под воздействием неблагоприятных факторов (лекарства, бактерии, вирусы) или в результате соматической мутации изменяется антигенная структура эритроцитов.
- Происходит взаимодействие между выработанными антителами и собственными антигенами, что приводит к иммунологическому процессу с развитием гемолиза (свободный гемоглобин больше не ограничен клеточной мембраной) и анемии (разрушенные красные кровяные тельца уже не являются эритроцитами, как и вышедший на свободу гемоглобин).
Иммунная агрессия на собственные клетки может быть вызвана различными антителами:
- Неполные тепловые агглютинины (в основном класс G – IgG, реже класс А), которые связываются с поверхностью эритроцитов и активизируются при температуре 37°С. Обычно при таком взаимодействии эритроциты не разрушаются в кровотоке, а направляются «умирать» в селезенку.
- Холодовые неполные агглютинины (класс М – IgM), которые взаимодействуют с эритроцитами при температуре 32°С с участием комплемента. Эти антитела необратимо разрушают эритроциты в мелких сосудах, где температура может опускаться до указанных значений (пальцы рук и ног, уши, нос).
- Двухфазные гемолизины (класс G – IgG) — антитела, которые находят свои антигены при охлаждении, связываются с поверхностью клетки и ждут повышения температуры до 37°С, после чего начинают проявлять агрессию (в результате — гемолиз).
Симптоматика АИГА разнообразна и зависит от множества факторов, включая:
- Скорость гемолиза (криз или «спокойствие»);
- Температурные условия (тепло или холод);
- Место разрушения эритроцитов;
- Изменения в внутренних органах;
- Наличие фоновой патологии.
К основным признакам АИГА относятся:
- Гемолитический криз с желтухой;
- Анемия (снижение уровня гемоглобина и количества эритроцитов);
- Повышение температуры тела;
- Наличие гемоглобина в моче;
- Увеличение селезенки.
Дополнительные симптомы:
- Слабость и утомляемость;
- Снижение аппетита;
- Увеличение печени.
Лабораторная диагностика АИГА включает биохимические исследования (билирубин), общий анализ крови (с подсчетом ретикулоцитов и определением осмотической резистентности эритроцитов) и анализ мочи. Обязательны иммунологические тесты (проба Кумбса), которые помогают выявить тип антител.
Лечение аутоиммунной гемолитической анемии в период кризиса проводится в стационаре. Пациент получает кортикостероиды и иммунодепрессанты. Если терапия неэффективна, может быть рассмотрен вопрос о спленэктомии.
Переливание компонентов крови (эритроцитарной массы) осуществляется только по жизненным показаниям и после индивидуального подбора (проба Кумбса)!
Видео: лекция по гемолитическим анемиям
Вопрос-ответ
Что такое гемолитическая анемия?
Гемолитическая анемия — это гетерогенное заболевание, которое характеризуется патологическим повреждением и последующим распадом эритроцитов (гемолизом). Различают наследственные и приобретенные гемолитические анемии, связанные и несвязанные с дефектом эритроцитов.
Что такое гемолитическая анемия и ее виды?
Гемолитическая анемия — это заболевание, при котором эритроциты разрушаются быстрее, чем синтезируются. Наследственная гемолитическая анемия означает, что родители передают ген этого заболевания своим детям. Приобретённая гемолитическая анемия не является врожденной. Она развивается позже.
Каковы методы лечения гемолитической анемии?
Лечение гемолитической анемии. При врожденных формах анемии проводят инфузии растворов и витаминов, гормонотерапию, удаление селезенки (по показаниям). Приобретенные формы заболевания требуют этиопатогенетической терапии, которая может включать глюкокортикостероиды, иммунодепрессанты, противомалярийные препараты.
Какие виды гемолиза существуют?
Гемо́лиз (от др.-греч. αἷμα «кровь» + λυσις «распад, разрушение») — разрушение эритроцитов с выбросом гемоглобина в плазму крови. Различают физиологический и патологический, внутриклеточный и внутрисосудистый.
Советы
СОВЕТ №1
Обратите внимание на симптомы: усталость, бледность кожи, одышка и учащенное сердцебиение могут быть признаками гемолитической анемии. Если вы заметили у себя или близких эти проявления, не откладывайте визит к врачу.
СОВЕТ №2
Регулярно проходите медицинские обследования, особенно если у вас есть предрасположенность к заболеваниям крови. Раннее выявление гемолитической анемии может значительно улучшить прогноз и облегчить лечение.
СОВЕТ №3
Следите за своим рационом. Убедитесь, что в вашем питании достаточно железа, витаминов B12 и фолиевой кислоты, так как они играют важную роль в образовании крови и могут помочь в профилактике анемии.
СОВЕТ №4
Обсуждайте с врачом возможные варианты лечения и следуйте его рекомендациям. Лечение гемолитической анемии может включать как медикаментозную терапию, так и изменение образа жизни, поэтому важно быть вовлеченным в процесс.